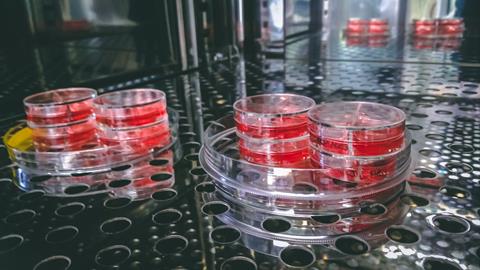
Cell,Culture,Dishes,Filled,With,Growth,Medium,In,A,Co2

The LiCellGrow cell expansion system enables real-time metabolic monitoring and automated culture optimisation to accelerate cell and gene therapy manufacturing.
PHC Corporation of North America (PHCNA) is set to present a prototype of its LiCellGrow Cell Expansion System at Advanced Therapies Week in Dallas, Texas, from January 20th to 23rd, 2025. The system, currently under development, is designed to enable pharmaceutical companies to visualise continuous metabolic changes within cells in real time. This will allow for automatic adjustment of cell culture conditions, ensuring optimal growth conditions and accelerating the production of the specific cells required for cell and gene therapy (CGT) treatments.
Cell and gene therapy has become a highly promising approach for treating complex, difficult-to-treat conditions such as cancers and hematologic disorders. Since these therapies often use the patient’s cells, maintaining consistent and high-quality cell production is critical. However, current manufacturing methods rely on manual sampling of the final product to assess cell quality, a process that can lower efficiency, yield, and increase production costs.
The LiCellGrow system is designed to address these challenges by enabling real-time monitoring and control of the cell culture environment. By providing continuous, precise measurement of key metabolic indicators like glucose and lactate, the system helps researchers maintain optimal conditions for cell growth, reducing the risk of contamination and improving the efficiency of the manufacturing process.
LiCellGrow integrates PHC's proprietary In-Line monitoring technology, which uses sensors submerged in the culture medium to measure cell metabolites at all times, eliminating the need for manual sampling. This innovative system will continuously monitor changes in the culture environment and adjust the conditions automatically, ensuring that the culture medium remains in an optimal state for cell growth. This automatic process not only improves cell quality but also helps reduce production costs by minimising waste and loss.
This development represents a strong synergy between PHC’s Biomedical and In Vitro Diagnostics (IVD) Divisions. The In-Line monitoring technology incorporated in the LiCellGrow system builds on PHC’s core expertise in blood glucose sensors, a technology developed by the IVD Division. By combining this with advanced cell culture technology from the Biomedical Division, PHC aims to offer valuable solutions to researchers and pharmaceutical companies engaged in the development of CGT products.
The Biomedical Division of PHC Corporation is planning to launch LiCellGrow in the short term to support global CGT product manufacturing. The system is expected to accelerate the development of manufacturing processes and eventually help commercialise CGT products, making these treatments more accessible to patients worldwide.







